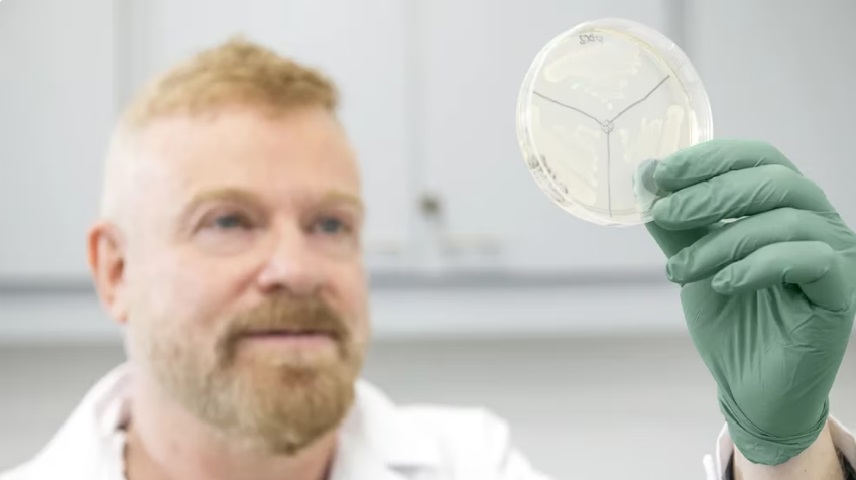

El doctor en inmunología Gabriel Rabinovich lanzó hoy la empresa biotecnológica con inversión público-privada en el Instituto de Biología y Medicina Experimental (Ibyme). Su objetivo es desarrollar terapias innovadoras contra el cáncer y las enfermedades autoinmunes basadas en una proteína clave: la Galectina-1. Los detalles de sus descubrimientos científicos.
Al decir de sus mentores, el científico argentino Gabriel Rabinovich es un hacedor que sueña y a la vez es un soñador que hace. Nada mal para un emergente brillante del sistema científico argentino que define sus logros por su enorme talento, por su disciplina para investigar y también por su humanidad y generosidad para saber formar historias colectivas en la ciencia con talentos transdisciplinares, jóvenes y pujantes. Un perfil muy completo y ejemplar, que no abunda.
Rabinovich es médico inmunólogo y glicobiólogo, y además es un inspirador nato. Apasionado de sus propios proyectos y de la ciencia transdisciplinar y de su formación en la universidad pública desde su Córdoba natal hasta Buenos Aires. Desde hace años está listo para dar el salto en las grandes ligas de la ciencia, y lo quiere hacer con su gente. Incluso, no esquivó a entender la importancia de las reguladoras para que los proyectos sean aprobados y obtengan patentes.
Le enseñó al mundo entero a ponderar y a pronunciar el rol de la proteína Galectina-1 (Gal-1) contra el cáncer y las enfermedades autoinmunes. Y es el científico argentino que más patentes acumula para que todas sus invenciones vuelvan como retorno económico a la ciencia argentina. Nada más claro en este tiempo: la ciencia es fundamental para el desarrollo de una nación.
En 1993, el doctor Gabriel Rabinovich identificó y purificó una proteína de unión de azúcares que tenía la particularidad de silenciar linfocitos T activados, células del sistema inmune responsables de atacar tanto a patógenos como a células tumorales. Ese fue el inicio de un camino que hoy se consumó en un centro de investigación (Galtec / Conicet)Con ese camino sobre sus espaldas hoy lanzó un gran proyecto biotecnológico en el primer piso del Instituto de Biología y Medicina Experimental (IByme), fundado en 1944 nada más y nada menos que por otro hombre inspirador de los científicos argentinos, el Premio Nobel Bernardo Houssay.
Hoy, uno de los grandes sueños de Gabriel Rabinovich desde hace muchas décadas se hizo realidad: la creación de una start up de base tecnológica a la que llamó Galtec. Como generador de ciencia y creador de líderes ha logrado enamorar a sus colegas que lo secundan en esta iniciativa de gran trascendencia para la ciencia argentina y del mundo: desarrollar productos terapéuticos basados en la proteína Galectina-1 (Gal-1) que permitan la generación de terapias contra el cáncer y graves enfermedades autoinmunes.
Así, en esta jornada lluviosa, se cristalizó el sueño del gran científico argentino, que sin duda puede convertirse en los próximos años en un nuevo Premio Nobel para el país. A través de este proyecto colectivo que imaginó durante décadas, pondrá a disposición del mundo su descubrimiento. Rabinovich tiene una amplia experiencia en el mundo de las patentes y la transferencia tecnológica y ya cuenta con varias al lanzar su nueva iniciativa.
Esta empresa biotecnológica transformará los hallazgos científicos del grupo de investigación dirigido por Rabinovich en nuevas oportunidades terapéuticas basadas en las interacciones galectina-glicanos para pacientes con cáncer y enfermedades del sistema inmunitario.
“Si lo podemos soñar, lo podemos lograr. Es cierto que los sueños son importantes, pero esta definición es al menos incompleta. Creo que solo se hacen realidad si se le da una oportunidad”, dijo Rabinovich en la presentación realizada esta tarde.
Asimismo, enumeró las oportunidades dadas por los hallazgos científicos previos que llevaron adelante él y sus equipos: “Los descubrimientos claves de nuestro laboratorio nos permitieron pensar en la posibilidad de generar Galtec. El laboratorio de Córdoba, donde nació nuestra ciencia; el del Hospital de Clínicas y el IBYME, que nos cobijó desde 2007. El primer paso fue la identificación y purificación de Galectina-1 (Gal-1), una proteína que se une en azúcares en el sistema inmune, a principios de los años ‘90″, recordó.
“Hoy parece que podemos encontrar un camino para poner la ciencia al servicio de la gente. Esto justifica el por qué es una inversión estatal, porque tiene que servir a todos. Esto también es generar trabajo, y que las empresas de base tecnológica tengan un destino en nuestro país”, señaló el Ministro de Ciencia, Tecnología e Innovación, Daniel Filmus, en el evento. Al tiempo que destacó “el liderazgo y capacidad de Rabinovich” y su voluntad de quedarse en Argentina “a pesar de los momentos difíciles que pasó en los 90″.
En diálogo con Infobae, Rabinovich fue contundente respecto al aporte de este centro de investigación biotecnológico: “Queremos asegurarnos que nuestras tecnologías tras años de investigación lleguen a quienes más lo necesitan, los pacientes, y a cada rincón de la Argentina, de Latinoamérica y del mundo. En este sentido, todas las tecnologías de Galtec poseen una amplia propiedad intelectual constituida por familias de patentes, que a través de un convenio firmado ante la concreción de diferentes hitos, permitirá generar retornos a los inventores, al CONICET, y a las instituciones involucradas estimulando de esta manera un circuito virtuoso”.
“El beneficio de la inmunoterapia hoy se encuentra restringida a un número limitado de pacientes con características particulares. Uno de los objetivos de Galtec es incrementar el número de pacientes que se beneficien de la inmunoterapia, para que vivan mucho más y mejor. Para esto una de las tecnologías que proponemos es un anticuerpo neutralizante que al bloquear Galectina-1 logra potenciar la respuesta inmunológica antitumoral”, detalló Rabinovich a Infobae.
“En una primera instancia avanzaremos en cáncer colorrectal, luego seguiremos por otros tumores. Por otro lado, teniendo en cuenta la capacidad de Galectina-1 de suprimir la respuesta autoinmune silenciando a poblaciones de linfocitos, proponemos una solución terapéutica y elegimos la esclerosis múltiple para avanzar”, completó.
El doctor Rabinovich, junto al equipo que lidera, en el nuevo centro biotecnológico contra el cáncer y enfermedades autoinmunes (Galtec / Conicet)El proyecto lanzado hoy tiene sus raíces cuando Rabinovich inició su tesis de doctorado, en 1993, en la Universidad Nacional de Córdoba (UNC) e identificó la ahora famosa proteína la Galectina-1. Esta tiene la habilidad única de silenciar linfocitos T activados, esas células del sistema inmune encargadas de combatir patógenos y células tumorales. El viaje del investigador argentino para descubrir esta proteína fue respaldado por otras mentes brillantes como Clelia Riera y Carlos Landa, y marcó el comienzo de una travesía que dio forma a Galtec.
La organización se inicia con el objetivo claro y principal de desarrollar productos terapéuticos basados en Gal-1. Con el objetivo de modular la actividad de esta proteína, “encenderla” o “apagarla”, según sea necesario para el tratamiento de cada enfermedad. Su estrategia se basa en bloquear la acción de la proteína Galectina-1, que favorece el crecimiento de los tumores y la inflamación.
Pero Rabinovich, quien ingresó a la Carrera del Investigador Científico y Tecnológico del CONICET a comienzos de 2002 tras un período como becario postdoctoral, le gusta llamar a GAL-1 “Dr. Jekyll y Mr. Hyde”, por el personaje de la novela de Robert Louis Stevenson. Porque “a veces juega el rol de villana, cuando ayuda a los tumores a eludir la respuesta del sistema inmune y otras el de heroína, al evitar la aparición de enfermedades autoinmunes”.
El ministro de Ciencia y Tecnología, Daniel Filmus, la presidenta del Conicet Ana Franchi, junto al doctor Gabriel Rabinovich, y al Presidente de la Agencia Nacional de Promoción de la Investigación, el Desarrollo Tecnológico y la Innovación, Fernando Peirano (Maximiliano Luna)La filosofía de esta mente brillante se basa en la investigación fundamental y rigurosa, buscando siempre esa conexión entre el laboratorio y la vida real. El equipo de Rabinovich ha cosechado una serie de descubrimientos desde el estudio inicial sobre Gal-1. Uno de los más impactantes se produjo cuando se experimentó Gal-1 en ratones con artritis y se vio cómo podría revertir los síntomas de la enfermedad. Ese estudio fue tan revelador que incluso apareció en el Journal of Experimental Medicine y fue mencionado en la revista Nature.
Así, este avance científico llevó a Rabinovich a explorar aún más el papel de Gal-1 en enfermedades autoinmunes y cáncer, obteniendo resultados significativos y publicaciones en revistas de renombre, como Cancer Cell y Cell. Vale destacar aquí que uno de sus hallazgos más notables es que Gal-1, además de suprimir el sistema inmunológico, facilita la formación de vasos sanguíneos que nutren los tumores. Y así lo habíamos resaltado en Infobae en 2014, cuando lo compartió con el mundo científico.
Ahora, el 2023 ha sido testigo de otro gran avance: la publicación de un estudio en Proceedings of the National Academy of Sciences (PNAS), que respalda y profundiza el trabajo anterior sobre Gal-1 y su relevancia en la lucha contra el cáncer. Rabinovich y su equipo demostraron, una vez más, que su determinación por mejorar la calidad de vida de los pacientes comienza a dar frutos.
Qué es Galtec y cuál es su misión
Galtec tendrá la misión de transformar los descubrimientos sobre el rol de las galectinas del laboratorio de Gabriel Rabinovich en nuevas estrategias terapéuticas (Galtec / Conicet)Como muchos investigadores, Rabinovich siempre tuvo el deseo de que sus trabajos científicos pudieran ayudar a mejorar la vida de los pacientes. En ese sentido, la creación de Galtec es un paso importante hacia la concreción de aquella vieja aspiración. Sin embargo, siempre consideró que la única forma de que ese objetivo se pudiera cumplir era primero hacer investigación fundamental rigurosa, que sirviera de base al desarrollo de nuevas estrategias terapéuticas. Los siguientes son algunos de los trabajos más importantes del equipo científico publicadas en revistas científicas internacionales
– Estudio sobre el rol de Gal-1 en enfermedades autoinmunes: hallaron que la administración de Gal-1 a ratones con artritis podría revertir los síntomas de la enfermedad. Fue publicada en la revista Journal of Experimental Medicine y destacado en un artículo de la revista Nature.
– Estudio sobre Gal-1 y cáncer: detallaron cómo Gal-1 ayuda a los tumores a escapar de la respuesta inmune. Fue publicado en la tapa de Cancer Cell bajo el título: “El dulce beso de la muerte: Galectina-1 y el escape inmune tumoral”.
A Rabinovich, le gusta asociar a Gal-1 con Dr. Jekyll and Mr. Hyde, el personaje de la novela de Robert Louis Stevenson, dado que, según afirma, “a veces juega el rol de villana, cuando ayuda a los tumores a eludir la respuesta del sistema inmune, y otras el de heroína, al evitar la aparición de enfermedades autoinmunes” (Galtec / Conicet)– Estudio sobre Gal-1 en la interfase materno-fetal: en el artículo se describió la interacción entre Gal-1 y sus receptores tienen impacto en componentes claves de la respuesta inmunológica. La publicación del paper se hizo en Nature Medicine.
– Estudio sobre Gal-1 en angiogénesis y cáncer: se describió el hallazgo en torno de que Gal-1. Además de ayudar a escapar a distintos tipos de cánceres de la respuesta inmune, crea vasos sanguíneos que permiten el crecimiento y metástasis de tumores. Fue publicado en la portada de Cell
– Relevancia clínica del trabajo anterior sobre Gal-1 fue descrito el bloqueo de VEGF, ya que Gal-1 puede promover la angiogénesis. La publicación se hizo en las actas Proceedings of the National Academy of Sciences (PNAS).
– Estudio sobre Gal-1 como regulador del sistema inmunológico: fue detectado como Gal-1 es un regulador jerárquico del sistema inmunológico y previene enfermedades autoinmunes vinculadas a la edad. La publicación también la hizo PNAS.
fuente: infobae